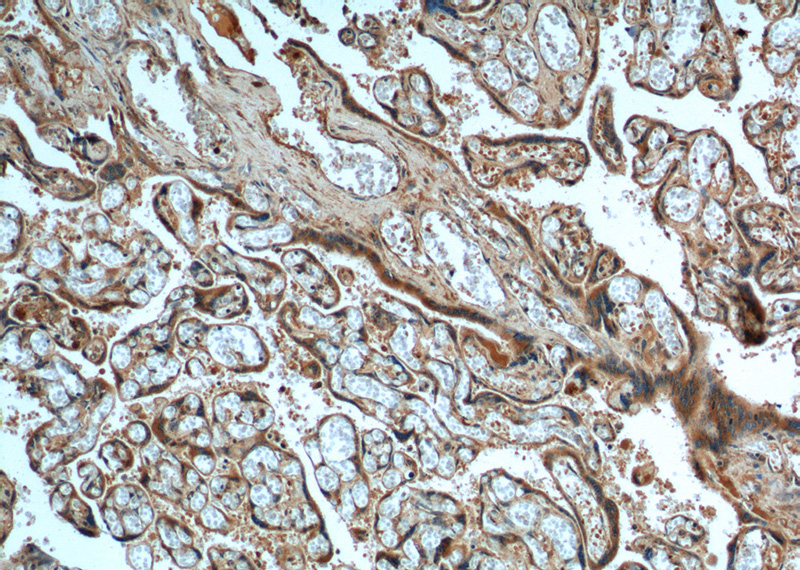
Immunohistochemistry of paraffin-embedded human placenta tissue slide using Catalog No:110794(FURIN Antibody) at dilution of 1:200 (under 10x lens).
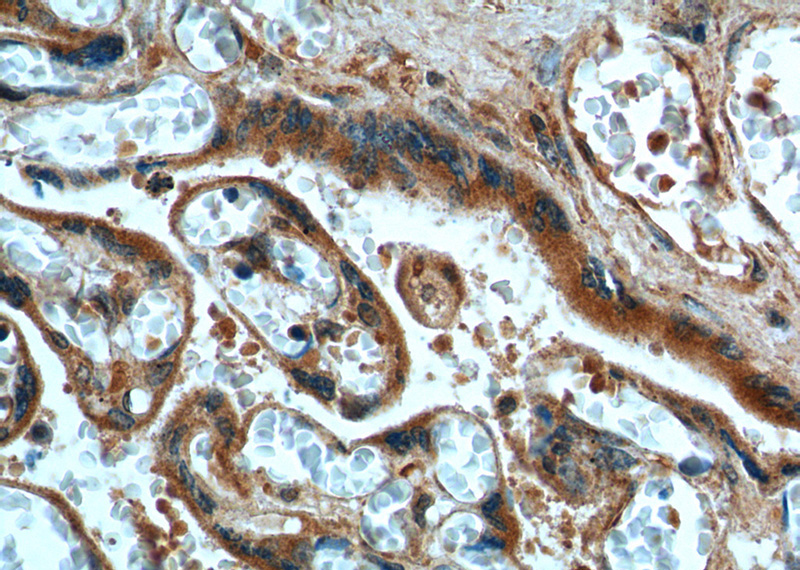
Immunohistochemistry of paraffin-embedded human placenta tissue slide using Catalog No:110794(FURIN Antibody) at dilution of 1:200 (under 40x lens).

-
Product Name
FURIN antibody
- Documents
-
Description
FURIN Rabbit Polyclonal antibody. Positive IHC detected in human placenta tissue. Positive WB detected in HeLa cells, COLO 320 cells. Positive IP detected in HeLa cells. Observed molecular weight by Western-blot: 90 kDa
-
Tested applications
ELISA, WB, IHC, IP
-
Species reactivity
Human,Mouse,Rat; other species not tested.
-
Alternative names
Dibasic prOCessing enzyme antibody; FUR antibody; FURIN antibody; PACE antibody; PCSK3 antibody; SPC1 antibody
-
Isotype
Rabbit IgG
-
Preparation
This antibody was obtained by immunization of FURIN recombinant protein (Accession Number: NM_001382619). Purification method: Antigen affinity purified.
-
Clonality
Polyclonal
-
Formulation
PBS with 0.1% sodium azide and 50% glycerol pH 7.3.
-
Storage instructions
Store at -20℃. DO NOT ALIQUOT
-
Applications
Recommended Dilution:
WB: 1:200-1:2000
IP: 1:200-1:2000
IHC: 1:20-1:200
-
Validations

HeLa cells were subjected to SDS PAGE followed by western blot with Catalog No:110794(FURIN Antibody) at dilution of 1:600

IP Result of anti-FURIN (IP:Catalog No:110794, 4ug; Detection:Catalog No:110794 1:500) with HeLa cells lysate 1400ug.
Immunohistochemistry of paraffin-embedded human placenta tissue slide using Catalog No:110794(FURIN Antibody) at dilution of 1:200 (under 10x lens).
Immunohistochemistry of paraffin-embedded human placenta tissue slide using Catalog No:110794(FURIN Antibody) at dilution of 1:200 (under 40x lens).
-
Background
FURIN, also named as FUR, PACE, PCSK3, SPC1, Kex2p, is likely to represent the ubiquitous endoprotease activity within constitutive secretory pathways and capable of cleavage at the RX(K/R)R consensus motif. Furin is synthesized as an inactive zymogen that may minimize the occurrence of premature enzymatic activity that would lead to alternative protein activation or degradation. Glycosylation and other post-translational modifications can make the pre-pro furin run at 100-110 kDa, the mature furin at 98-95 kDa and shed furin at 90 kDa.
Related Products / Services
Please note: All products are "FOR RESEARCH USE ONLY AND ARE NOT INTENDED FOR DIAGNOSTIC OR THERAPEUTIC USE"
